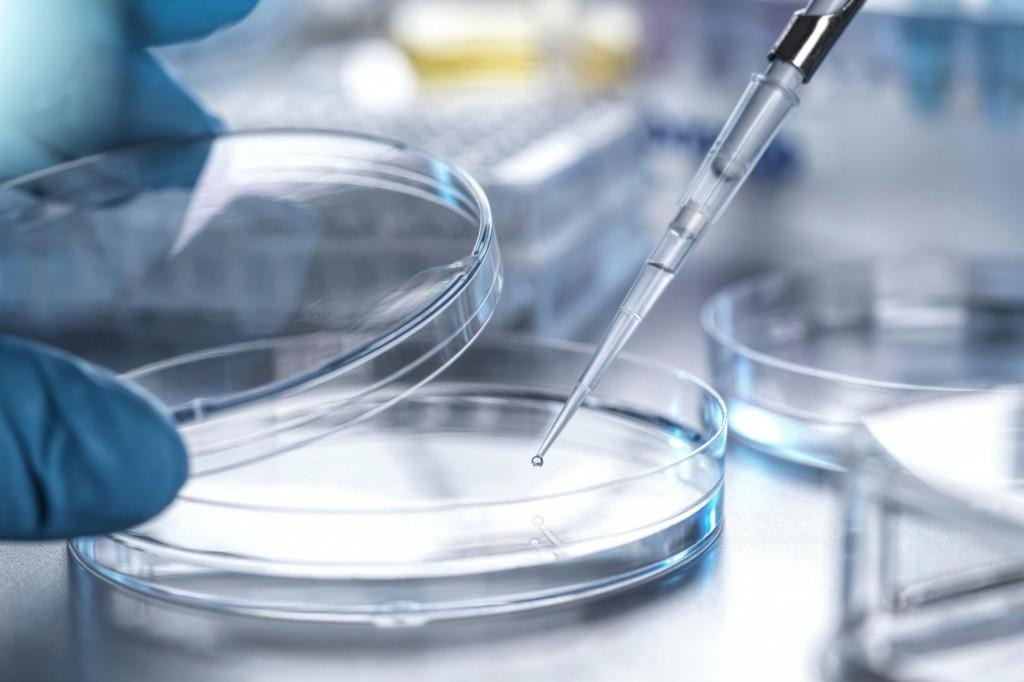

Apoptosis is a form of cell death, and it is quite important in cellular and cancer biology, because studying it helps scientists better understand how tumors respond to stress, mutations, as well as therapy. To better understand apoptosis, a lot of labs rely on caspase-3 inhibitors, such as Z-DEVD-FMK, as it is a rather important reagent that can help with various things during the research process. If you are a scientist yourself, and if you’re interested in understanding apoptosis better, then chances are that you’ve already come across Z-DEVD-FMK Caspase-3 inhibitor or similar substances that can help in the researching process.
What’s more, you are most likely also interested in getting this reagent for your lab. And, well, while that is a good plan, you should undeniably not rush into it. This is because rushing into it can result in you making certain mistakes that could be quite detrimental, and that could result in your studies not being that reliable and precise. Since that is not what you want, there is no doubt in my mind that you want to do your best to avoid those mistakes.
Of course, in order to be able to avoid them, you will first have to learn about them, and that is what we are going to be talking about below. Yet, not before we actually ensure that you understand what Z-DEVD-FMK Caspase-3 inhibitor is, and why it matters in research. Once we cover that, we will be ready to proceed towards getting you familiar with those potential mistakes, and thus helping you avoid them. Without any further ado, thus, let us start covering the important topics.
What Is Z-DEVD-FMK Caspase-3 inhibitor?
We are, clearly, going to begin with the very basics here. So, what exactly is Z-DEVD-FMK Caspase-3 inhibitor? In short, it is a peptide-based inhibitor that covalently binds to the active site cysteine and thus irreversibly inhibits the Caspase-3 enzyme.
The fact that it is cell-permeable means that it can enter the live cells and thus block Caspase-3 activity intracellularly. And, while it was specifically designed for Caspase-3, it can actually, at higher concentrations, inhibit related caspases as well. Z-DEVD-FMK Caspase-3 inhibitor is a widely used reagent that can help you model apoptosis, and study various things, from neuroprotection to ischemia and others. This kind of versatility, and the fact that it can help scientists better understand the programmed cell death known as apoptosis is precisely what it is so important in research, and why you may want to think about getting it for your lab, in order to study various processes.
Mistakes to Avoid When Getting It
If you have already decided that you want to get it, let us now turn our attention towards that other topic we have hinted at above – the main one for today. In short, I am talking about the idea that you can make some crucial mistakes in the process of actually getting this reagent. And, since it is clear that you want to avoid them, let us now get you familiar with them, in an effort to help you understand both what you should and what you shouldn’t do when trying to get the perfect reagent for your lab.
- Choosing a Random Supplier
One of the things that people usually do is this. They assume that all chemical suppliers are the same, and they just randomly select one, without doing any kind of research whatsoever. This, however, is not a good idea, and you should undeniably be quite more careful than that. So, this is the first mistake you should avoid, and I am sure that you will keep it in mind, and thus, be more cautious when the time comes for you to decide where to buy Z-DEVD-FMK Caspase-3 inhibitor.
Here is an overview of this reagent, in case you need some more details: https://www.sciencedirect.com/topics/medicine-and-dentistry/caspase-3-inhibitor
- Not Checking for Quality Documentation
Now, you get that making random choices is not the smartest move. But, you may still be unsure of what kinds of things you actually have to check when trying to choose the right supplier. And, well, not checking for quality documentation is another mistake that could kind of sneak up on you, and that could lead to some quite serious consequences. What could happen?
Well, for one thing, if you don’t check for the quality documentation, you could wind up with an impure compound that will mess up your research and your results. Then, there is the chance of the reagent being mislabeled, leading to you getting something completely different, which is another thing that you definitely want to avoid. How can you avoid it, though?
That should be quite clear already. Basically, the idea is for you to choose those suppliers that provide a full Certificate of Analysis (CoA). Then, you should ask for batch to batch consistency information. And, whatever you do, you should avoid those shady vendors that cannot provide you with the info you need.
- Not Checking Reputation
Not inspecting the reputation of the suppliers is another crucial mistake that I am sure you would much rather avoid. After all, if you don’t check reputation, that can be a sure path towards partnering up with those shady vendors that won’t have your best interest in mind. And, that’s not how you form a good partnership. So, take your time to read some reviews and check how reliable and trustworthy certain vendors really are.
- Not Preparing Good Storage Conditions
On your end, you should not forget to prepare good storage conditions for the Z-DEVD-FMK Caspase-3 inhibitor you are getting. Check the supplier recommendations for storing this reagent, and then make sure to follow the instructions. Because, if you don’t, you risk decomposition, hydrolysis, as well as some unintended reactions with the reagent and the container walls or the solvent.
- Buying a Large Quantity Right Away
Finally, you should never buy a large quantity right away, even if you may need it. When partnering up with a new vendor, you first want to check the quality of what they are offering. So, order small, evaluate, and then order a large quantity if everything winds up being to your liking.



